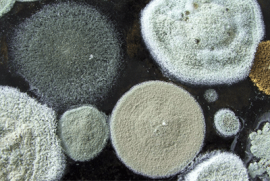

Осторожно, коварный враг!
Советы потребителям / Приказано выжить

Согласно данным Департамента здравоохранения (DOH), более 500 тысяч американцев ежегодно подрывают здоровье из-за регулярного контакта с плесенью (mold). Этот коварный грибок провоцирует самые разные недуги – от аллергических реакций и глубокой депрессии до развития хронических и неизлечимых заболеваний. Самое интересное, что миллионы жителей Соединенных Штатов даже не знают, что ухудшение их состояния связано именно с плесенью, которая отравляет свежий воздух, превращая его в ядовитый химикат замедленного действия.
«О разрушительной силе плесени говорилось ещё в Библии, - подчёркивает специалист по лёгочным болезням Вэл Конрад. – Эта малозаметная субстанция, состоящая из микроорганизмов, является одной из самых живучих на планете. Однако современная цивилизация уделяет ей слишком мало внимания. Как показывают опросы населения, американцы гораздо больше боятся тараканов, клопов, и комаров, чем плесени. Многие люди приравнивают плесень к пыли, считая её одной из разновидностей грязи. В реальности же плесень в жилище не менее страшна, чем ртуть, вытекшая из разбитого градусника».
По мнению исследователей, даже незначительный контакт с плесенью может привести к таким страшным заболеваниям как рак и туберкулёз, если иммунитет человека ослаблен, а концентрация плесневых грибков чересчур высокая.
Показательный случай произошёл в штате Северная Дакота. Семья из пяти человек уехала в отпуск на 24 дня. Временно оставляя дом, они допустили одну маленькую оплошность: оставили на раковине и в ванной несколько мокрых полотенец. За время их отсутствия грибок в жаркой и душной обстановке покрыл всю поверхность ванны.
Когда жильцы вернулись из отпуска и бросились оттирать чёрно-серую плесень без специальных масок, все пятеро в течение недели оказались в госпитале с серьезными диагнозами.
«По степени опасности плесень можно сравнить со стихией огня или воды, - говорит Ян Робертсон, специалист по сушке домов. – Это не просто грибок - это разрушительная сила. Если вы потеряете над ней контроль, то она разрушит всё – начиная с вашего имущества и заканчивая здоровьем. Страховые компании практически никогда не покрывают ущерб от плесени. Она для них является более сильным врагом, чем пожар или наводнение».
В летний период говорить о борьбе с плесенью особенно важно. Высокая температура и духота всегда приводят к влажности и недостатку вентиляции в закрытых помещениях. Это идеальная среда для молниеносного размножения плесневых грибков. Поэтому всем жителям квартир и особенно частных домов необходимо усвоить семь важных правил.
Во-первых, всегда держите поверхности сухими.
Это касается абсолютно всего – полов, мебели, раковин, бытовой техники и т. п. Многие американцы совершают большую ошибку, когда во время уборки не вытирают поверхности насухо, давая им возможность самостоятельно засохнуть. Именно так влага попадает под плинтуса, стены, щели между мебелью и т. п. Трудно в это поверить, но одна неправильная влажная уборка может привести к тому, что однажды вы обнаружите плесень под паркетом, ламинатом, плиткой, камнем и другими покрытиями.
Во-вторых, воздух в ванной должен иметь такую же степень влажности как и в гостиной.
Чтобы это проверить, закройте дверь в туалет на три часа, а потом зайдите в него. Если почувствовали влажность и перемену температуры, то «плесневая атака» - вопрос времени. Помните, что в 94% случаев уничтожение дома плесенью начинается с ванных комнат (особенно в недвижимости с центральным кондиционированием).
Если в туалете нет качественной вытяжки, то срочно купите бытовой фен-кондиционер, понижающий влажность (Humidity Exhaust Bathroom Fan). Стоят такие устройства от $80 до $230. Даже при ежедневном использовании они прослужат минимум пять лет.
В-третьих, поддерживайте воздух в помещении на уровне 70–74 градусов по Фаренгейту.
Примерно 14% жителей самых жарких регионов Америки включают кондиционер в мае, а выключают аж в сентябре. Техника работает круглосуточно, даже когда в жилище никого нет.
Минус такого неэкономного использования кондиционера – большие счета за электричество. Плюс – увеличение продолжительности жизни недвижимости и профилактика плесени.
Без кондиционера практически невозможно выжить астматикам и людям с ослабленным иммунитетом. Чем больше вы экономите на кондиционере, тем ближе подбирается к вам плесень.
В четвёртых, обеспечьте циркуляцию воздуха в доме.
Иногда даже кондиционеры, вентиляторы и вытяжки не могут обновить весь воздух в жилом помещении.
Так семейство Мэдвуд из Южной Каролины долго не могло понять причину странного запаха в дальнем углу гостиной. Отодвинув от стены старый шкаф, они ужаснулись. Плесень насквозь проела заднюю стенку мебели и деревянную стену аж на 10 дюймов. Общий вес отправленного в мусорный мешок чёрно-зелёного мха превысил 28 фунтов.
Строители оценили ремонт в $40 тысяч и подчеркнули, что причина появления плесени – затхлый воздух, который со временем начинает выделять столь необходимую грибку влагу. Подобное, например, очень часто происходит даже в самых ухоженных подвалах.
Хорошим решением проблемы является установка антиконденсатных окон и блокираторов (storm/thermal pane).
В-пятых, держите систему кондиционирования в чистоте.
В своё время эпидемиологи США хотели законодательно запретить торговлю бывшими в употреблении кондиционерами, поскольку 70% из них имели толстый слой плесени на вентиляторе и других внутренних частях. Конгресс, однако, посчитал, что смертность от жары среди малоимущих может увеличиться, поэтому благом потенциально правильный запрет не станет.
Тщательно проверяйте с помощью фонарика внутренности вашего оконного кондиционера, системы центрального кондиционирования, вытяжек на кухне и в ванной. Если увидели чёрно-серые пятна – выключайте технику и осторожно чистите с помощью средств бытовой химии. Если плесени слишком много и воздух пахнет гнилью/сыростью, то технику надо срочно менять.
В-шестых, используйте по назначению и для профилактики антиплесневые аэрозоли (Mold Inhibitors).
В магазинах стройматериалов и бытовой химии вроде Lowes и Home Depot они стоят всего $6 - $7 за штуку. Распыляемая жидкость прекрасно удаляет все известные виды плесени и препятствует её распространению.
По мнению медиков, Mold Inhibitors – одно из самых эффективных изобретений в многовековой борьбе с грибком.
Некоторые виды антиплесневых субстанций можно добавлять в стройматериалы – например, в краску, лак, штукатурку, замазку и т. п.
В-седьмых, равнодушный к плесени платит дважды.
Грибок опасен не только для вашего здоровья, но и для вашего кошелька. Если в ходе инспекционной проверки выставленного на продажу апартамента/дома выяснится, что в нём поселился грибок – вам придётся снизить цену.
Так вы можете потерять 10% его рыночной стоимости, а можете и все 100%.
Именно так, например, произошло в Детройте (Мичиган) после кризиса 2007 – 2008 года. Тысячи домов были отобраны банками и простояли без хозяев более года. Как результат, свыше половины из них уничтожил грибок.
Об этом научно-популярные каналы даже сняли несколько поучительных документальных фильмов. Новые покупатели уже приобретали не дома, а землю с объектами недвижимости, которые не подлежат ремонту. Им было выгоднее снести постройки и отстроить всё заново.
Напоследок хочу напомнить всем читателям «РБ» старый советский слоган, пропагандирующий здоровый образ жизни: солнце, воздух и вода – наши лучшие друзья.
В современной Америке он не потерял актуальности. И если дозировка солнца зависит от погодных условий, а вода – от чистоты труб, идущих из горной местности (в Нью-Йорке, к счастью, воду можно пить из-под крана), то качество воздуха в первую очередь определяется именно отсутствием плесневых грибковых спор. Как показывают исследования, бороться с этой заразой гораздо важнее, чем с выхлопными газами, табачным дымом и частицами пыли вместе взятыми.
Максим Бондарь

























